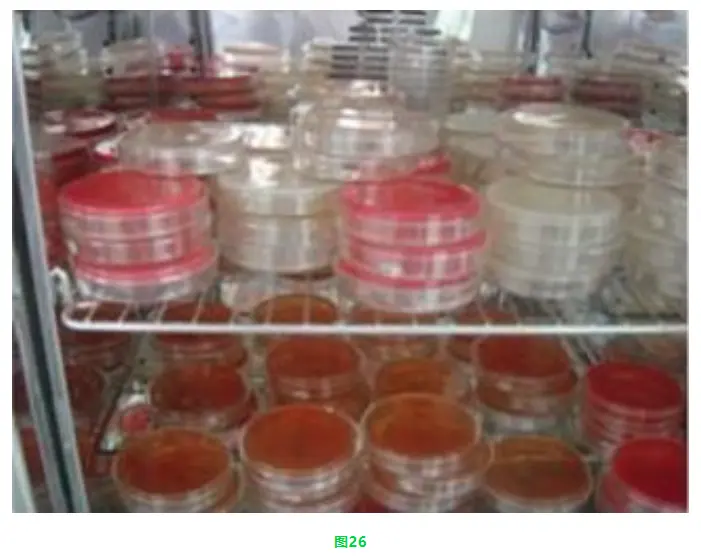
培养

微生物取样、样品制备技巧及稀释、接种、培养方法汇总!
发布时间:2022-08-22 浏览次数:5400
一、取样准备
(1)取样时该样品必须是代表该批产品情况。
从车间取回样品冷冻品按要求进行解冻,干燥食品可放在常温冷暗处,易腐和冷却样品应放入10℃环境。冷冻样品来不及检验应放入-15℃以下冰箱内,待检样品存放时间不应超过36h。
(2)解冻
原则上冷冻样品取出后,按包装原样在室温下自然解冻;也可在0-4℃环境解冻,时间不超过18小时;也可在温度不超过45℃环境中解冻,时间不超过15min。如果这些解冻条件对有些产品尤其是大块冷冻品达不到解冻的目的,可参照以下解冻时间。
① 100-300g调理食品45℃解冻10min左右;
② 500g以下冷冻蔬菜30℃解冻40min左右;
③ 500g以上冷冻样品37℃解冻1h左右;室温下解冻2h左右。
※ 备注:将样品解冻到半解冻状态(用剪刀能剪开的程度)。
(3)操作环境
试验前用臭氧发生器/紫外线将工器具、无菌间灭菌消毒,达到无菌状态。
操作试验的准备物品均质袋、酒精及酒精棉、吸管、平皿、稀释液、剪刀、镊子、无菌盆等物品是否齐全。
二、取样及样液制备
1 样品标识
将样品从污染程度低到污染程度高的顺序排列,相应的作一一对应性标识,其中按细菌数平皿、大肠菌群平皿、金黄色葡萄球菌平皿的顺序,2-3个样品一摞。如图1:

2 检样采取
先将样品外包装正反面用酒精喷洒(如果样品表面有冷凝水先擦拭干净后再用酒精喷洒),如图2:

(1)固体样品
① 75%酒精棉消毒开启部位及其周围,再用火焰灭菌的剪刀剪开,如图3。

② 在电子称上放入无菌均质袋(手不要碰及袋口)去皮调整至零,如图4。

③ 用火焰灭菌后的剪刀和镊子取样,称取25g有代表性样品,如图5、6、7、8、9。

④ 加入225ml灭菌磷酸盐缓冲液(开盖瓶塞时瓶口部和瓶塞应在火焰通过1-2次,以杀灭从空气中落入杂菌)后,均质或待均质,如图10、11、12。

⑤ 擦拭干净剪刀镊子后浸泡于75%酒精容器中并将样品封口。
⑥ 将袋子折叠后用拍击式均质器均质约30秒作为样液,此时均质袋内要设定为不含空气(可根据样品不同情况相应调整均质时间),如图13、14。

(2)液体样品
① 冷冻样品完全解冻后使用。
② 75%酒精棉消毒开启部位及其周围,再用火焰灭菌的剪刀开启,用灭菌吸管取充分混合后样25ml。
③ 余同上
(3)粉末状样品以及半固体样品
① 将样品混合均一化。
② 75%酒精棉消毒开启部位及其周围,再用火焰灭菌的剪刀开启,以无菌匙采取混合后样10g。
③ 加入90ml灭菌磷酸盐缓冲液,开盖瓶塞时瓶口部和瓶塞应在火焰通过1-2次,以杀灭从空气中落入杂菌。
④ 余同上。
※ 备注:
(1) 从罐头取样时,在表面放上小块酒精棉(倒上少量酒精)点火燃烧后开罐。罐头起子用酒精棉擦拭火焰灭菌后使用。
(2) 75%酒精必须保证一周换3次,如果容器内有明显的污物应立即更换。
(3) 火焰灭菌的剪刀、镊子通过火焰4-5s即可。
三、稀释方法
①从均质袋准确吸取样液1mL,如图15。

②沿管壁徐徐接种到含9mL磷酸盐缓冲液里,盖上试管塞后充分震荡混匀为1:100稀释液。(勿使吸管尖端伸入稀释液内,以免吸管外部粘附的检液溶于其内。)
③重复该操作,按需要配制1:1000、1:10000…稀释液。
④为减少样品稀释误差,在连续递增稀释时(原液在前稀释液在后),每一稀释液应充分振摇,使其均匀,同时每一稀释度应更换一支吸管。
⑤不要在稀释剂中吹洗吸管。
※ 备注:
(1) 样液稀释必须加以足够震摇,确保液体混匀,形成的菌落能以10倍递增或递减,符合逻辑性。
(2) 车间产品根据加工工艺或对污染情况的估计选择合适的稀释倍。(尤其注意葱、姜、蒜等无加热类产品、保存实验、外调新厂家、样品开发、原料等样品)。
四、样液接种方法:
① 从吸管筒沿筒上壁抽出吸管,在火焰旁吹洗吸耳球同时在吸管尾端插上吸耳球后,从吸管尾端至尖端快速通过火焰,并且排空吸管里残留的水,如图16、17、18。

② 以吸管插入均质袋样液内的深度不超过2.5cm处,准确吸取样品匀液(吸管尖不要碰着袋口。吸入的液体应先高于所要求的刻度, 然后提起吸管使其尖端离开液面并贴在袋内将液体调至所要求的刻度。)1mL、1mL、1mL、0.2mL无菌操作分别以2~4s内完全注入已标识清楚的细菌数、大肠菌群、EC以及金黄色葡萄球菌平皿中(EC接种后应迅速震荡均匀),图19、20、21、22。

③ 如果某一样品液在接种前放置时间超过3 min,应重新均质。
④ 为了验证稀释液、培养基、平皿、吸管等器具无菌需做空白对照。
五、倾注倒药方法
右手持培养基三角瓶(已放50-60℃的水浴中恒温)置火焰旁边,用左手拇指和食指或中指使平皿开启成一缝,迅速倒人培养基约15ml,加盖后轻轻摇动培养皿,使培养基均匀分布在培养皿底部,然后平置于桌面上;也可将平皿放在火焰附近的桌面上用左手的拇指和食指打开培养皿,再注入培养基,摇匀,如图23、24、25。

※备注:
(1)培养基在50-60℃水浴中的保温时间不要超过4h。
(2)从采样开始到分注培养基操作限于20min以内。
(3)涂布的平皿表面需干燥(干燥不充分易发生菌落扩散,有冷凝水不利于细菌分离并且会导致细菌繁殖使结果失真;干燥过分,会导致培养基裂开,不能用;干燥合适,则样液吸收完全、快)。
(4)细菌容易吸附在玻璃器皿的表面,所以菌液注入平皿后应尽快将平皿内的样液和琼脂培养基充分混合,否则细菌不容易分散。混合方法是将平皿倾斜和旋转使之充分混合,但要注意不要让培养基从培养皿内溢出,且不要粘附在平皿壁和盖上。
六、培养
● 平皿倒置放入恒温培养箱中(每垛最多堆放6个平皿,平皿间要留有空隙进行空气流通,使培养物的温度尽快与培养箱温度达到一致),按所规定的时间温度进行培养。培养箱应保持一定的湿度,经48h培养的琼脂培养基的失重不得超过15%,如图26。
● 斜面、高层斜面、液体培养基立在试管架上放入恒温培养箱中,按所规定的时间温度进行培养,如图27。

七、计数判定及注意事项
●由于细菌种类繁多,差别甚大。计数时一般用透射光于平皿背面或正面(菌落计数器)仔细观察。必要时用放大镜检查,以防遗漏尤其是平皿边缘生长的菌落。
●计数方法参照SN/T 0168-2015方法。
●稀释度低的培养皿,微生物菌落和食品碎渣很难区分,一般以食品碎渣没有光泽,不够光滑来识别。
●为了避免食品中的微小颗粒或培基中的杂质与细菌菌落发生混淆,不易分辨,可同时作一稀释液与琼脂培基混合的平板,不经培养,而于4℃环境中放置,以便计数时作对照观察。
● 必要时,为了防止食品颗粒与菌落混淆不清,可在平板计数琼脂中加入氯化三苯四氮唑TTC(100ml加入1ml 0.5%TTC),培养后菌落呈红色,易于分别。
● 在发酵试验中,发酵倒管的产气量,多者可以使发酵倒管全部充满气体,少者可以产生比小米粒还小的气泡,或发酵时产酸或沿管壁有缓缓上浮的小气泡,都应作进一步试验。如果对产酸但未产气的发酵有疑问时,可以用手轻轻打动试管,如有气泡沿管壁上浮,就像啤酒中的二氧化碳气泡一样,即应考虑可能有气体产生,而应作进一步试验。如果只是摇起的气泡,就是阴性。
